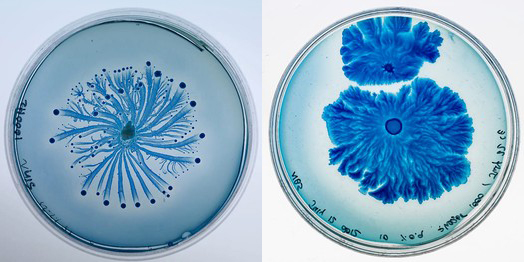

Research Writing
Introduction
0.1 Motivation
If the question of Being was the central issue for antiquity (resurrected in the twentieth century by Heidegger) and if the question of God, as alive or dead, was the central issue of modernity (Kierkegaard, Marx, Nietzsche), then perhaps the question of “life” is the question that has come to define our contemporary era…[1]
[1] Thacker, Eugene, After Life. Chicago and London: University of Chicago Press, 2010.
In 1738, when Jacques Vaucanson first presented his eating, drinking and digesting mechanical duck to the French court[2], he posed the following question: is a technological imitation of life life[3]? Today, technology is enabling us to achieve far more than we’ve ever imagined, and with new developments in fields such as artificial life and bioengineering, the science fictions of yesterday have become realities of today. In a world where computer systems have the capacity to learn and resemble living systems, where we can clone our own meat[4][5] and grow our own clothes[6], what then differentiates the organic from the artificial and the living from the dead? The goal of this thesis is to explore possibilities of creating hybrid systems between the organic and the technical that questions conventional boundaries between living and non-living, object and subject.
[2] Jacques de Vaucanson's Mechanical Duck, 1739

[3] Riskin, Jessica. "The Defecating Duck, or, the Ambiguous Origins of Artificial Life". Critical Inquiry, Vol. 29 No. 4. Summer 2003.
[5] Catts, Oron and Ionat Zurr. "Growing Semi-Living Sculptures: The Tissue Culture & Art Project. Leonardo, Vol. 35 No. 4. 2002.
Artists have always been interested in the philosophical debates and technological achievements of the day. Whether working with microbes, semi-living tissue, independent organisms or ecological systems, art practitioners are faced with the challenges of understanding the logic of these new materials, the logic of the bios. At the same time, they are left to grapple with implementing scientific methodology into their own artistic approach. DNA sequencing is increasingly cheap and accessible, which has allowed artists to utilize this method and even modify it for creative purposes. In his work Ocular Revision, Paul Vanouse experiments with new ways of visualizing DNA data[7]. In her bacterial textile works, Anna Dumitriu developed a method of culturing bacteria where living colonies become patterns of a larger fabric. In her bacterial textile works, Anna Dumitriu developed a method of culturing bacteria where living colonies become patterns of a larger fabric[8]. By hacking into the colony’s communication system, Nurit Bar-Shai was able to alter the growth patterns of bacterial colonies to form fractals[9][10].
[9] Nurit Bar-Shai, Paenibacillus vortex bacterium
[10] Myers, William and Paola Antonelli, Bio Design: Nature + Science + Creativity. New York: The Museum of Modern Art, 2012.
Within this context, my own interest lies in the relationship between electricity and life. Between the 1780s and 1790s, Luigi Galvani conducted a series of experiments where he stimulated frogs with electric charge and in doing so was able to animate their legs[11][12][13]. This “resurrecting” effect evoked mystical belief in the vitalizing powers of electricity as well as inspired writers such as Mary Shelley to create the novel Frankenstein. Surface charge properties play an important role in understanding how microorganisms behave and interact with their environment. Bacteria determine nutrient surfaces through detection of the charge on that surface[14]. Electricity has the potential to act as a medium for communication with the living system. It is this electric life that I am interested in exploring.
This thesis seeks to investigate and present the historical, philosophical and cultural aspects of the techno-organic hybrid, put forth questions for further discussion, and present previous and current explorations in designing such systems and interfaces.
[11] Bertucci, Paola. "Sparks in the Dark: The Attraction of Electricity in the Eighteenth Century". Endeavour Vol. 31 No. 3. 2007.
[12] Elsenaar, Arthur and Remko Scha. "Electric Body Manipulation as Performance Art: A Historical Perspective". Leonardo Music Journal Vol. 12. 2002.
[13] Luigi Galvani, Animal Electricity

[14] Foong, Lee Poh. "Electrophoretic Studies of Surface Charge on Unicellular Bacteria". Faculty of Science, University of Malaya Kuala Lumpur. April 2009.
0.2 Overview
Claus Emmeche suggests the existence of at least three non-exclusive notions of life: 1) Lebenswelt life, or lifeworld, is the concept of life based on culturally specific notions of what it means to be “alive” presented via narrative phenomenon. 2) Biological life, is interested in the general physical, chemical and biological properties of living processes studied in science, which based on different scientific disciplines, lead to differing definitions of life such as life as evolutionary replicators, life as autopoiesis, life as sign systems, etc. 3) Ontological life, addresses life from the metaphysical perspective of reality[15]. The research and experimentation presented in the following touches on all three aspects of life mentioned above. Though it is far too ambitious to claim a thorough investigation, this thesis does seek to build a elementary understanding of life in relation to technology from all three aspects that provides foundation for further exploration.
[15] Emmeche, Claus. "A-Life, Organism and Body: The Semiotics of Emergent Levels". Ninth International Conference of the Simulation and Synthesis of Living Systems. September 2004.
My research began with four main domains concerning organic life and artificial intervention: philosophical, moral, art + culture, and science + technology (see Fig.1). The philosophical domain mainly directs investigation towards metaphysical discussions on the organic and the artificial throughout history. The morality section looks into ethical debates in Posthumanist and biopolitical theory concerning the technological organism. The areas of science and technology focuses on understanding life materials, past and present, as well as the technologies applied in manipulation of life forms. Art and culture examines the use of living organisms in artistic practice, and questions the meaning behind such interventions into the life process.
 Fig.1 Diagram of Domains
Fig.1 Diagram of Domains
The research section of this paper organizes work within the respective domains into four chapters.
Chapter 1 introduces the philosophical discourse of life from the perspective of the machine and the organism, and advances my interest in superlative life – life that is beyond the human experience.
Chapter 2 examines biomedia as a medium for art from the angle of the body. Through the investigations of the body throughout western culture, I put forth an open systemic perspective that points to possible new relationship between artist and artwork.
Chapter 3 considers the aesthetic use of biomedia from a temporal perspective. The reality of the organism is analyzed and dissected from a time-based media stance where the meaning behind technical intervention is questioned.
Chapter 4 presents my application of this research that mainly manifests in the work Living Devices. The creative process is divided into two stages: the first conveys ideas for an insect computation network, while the second presents experiments with E. coli bacteria.
Chapter 5 concludes my research and advances future goals for further development.
Chapter 1-3 resides in the research section of this website, while chapters 4 and 5 are presented in the documentation section.
0.3 Contributions
This thesis contributes to the field of animal-machine interface design and research. It proposes an aesthetic approach to creating technology for far-from-human organisms that abandons an anthropocentric point of view in favor of a decentralized systemic design strategy. A main inclination is to explore the idea of designing for selforganizing systems that are unpredictable and question the role of the artist and the nature of technological control within this context.
Furthermore, experimentation with electricity and bacteria have led to the development of a set of protocols and mechanisms for transforming the petri dish into a device that can be easily plugged in with electronics. Another technical outcome is the design of an electric voltage stimulation system that can produce non-unified, diverse and possibly dynamic voltage fields for stimulation purposes.
Bibliography
Thacker, Eugene, After Life. Chicago and London: University of Chicago Press, 2010.
Riskin, Jessica. "The Defecating Duck, or, the Ambiguous Origins of Artificial Life". Critical Inquiry, Vol. 29 No. 4. Summer 2003.
Catts, Oron and Ionat Zurr. "Growing Semi-Living Sculptures: The Tissue Culture & Art Project. Leonardo, Vol. 35 No. 4. 2002.
Myers, William and Paola Antonelli, Bio Design: Nature + Science + Creativity. New York: The Museum of Modern Art, 2012.
Bertucci, Paola. "Sparks in the Dark: The Attraction of Electricity in the Eighteenth Century". Endeavour Vol. 31 No. 3. 2007.
Elsenaar, Arthur and Remko Scha. "Electric Body Manipulation as Performance Art: A Historical Perspective". Leonardo Music Journal Vol. 12. 2002.
Foong, Lee Poh. "Electrophoretic Studies of Surface Charge on Unicellular Bacteria". Faculty of Science, University of Malaya Kuala Lumpur. April 2009.
Emmeche, Claus. "A-Life, Organism and Body: The Semiotics of Emergent Levels". Ninth International Conference of the Simulation and Synthesis of Living Systems. September 2004.